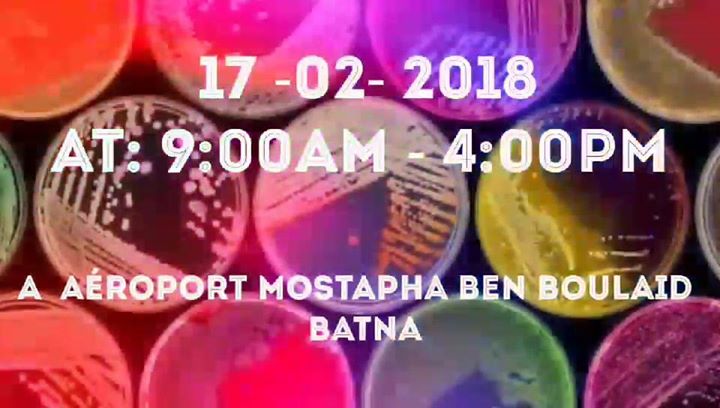
Anti-Microbial Resistance Campaign (AMRC)

C’est une compagne de sensibilisation lancée par l'une des organisations mondiales "IPSF" et parrainée par l'association Algérienne ARPEC (Batna).
C’est un projet de santé publique qui a comme but de sensibiliser le grand public notamment les patients , sur la menace grandissante que représente l'existence de bactéries potentiellement mortelles qui deviennent résistantes aux médicaments antimicrobiens, en particulier aux antibiotiques.
Notre équipe va être chapeautée par des experts de santé, des pharmaciens surtout,
• Compagne de sensibilisation ( Objectifs ) :
- Communication directe avec le grand public
- Communications affichées, et ateliers ( workshops )
- Prise de tension
Aéroport de Batna - Mostepha Ben Boulaid, Aéroport de Batna - Mostepha Ben Boulaid, 05000, Batna
2018-02-21 - 09:00:00+0100
2018-02-21 - 16:00:00+0100
Voir l'événement
-
Votre commentaire
Votre commentaire s'affichera sur cette page après validation par l'administrateur.
Ceci n'est en aucun cas un formulaire à l'adresse du sujet évoqué,
mais juste un espace d'opinion et d'échange d'idées dans le respect.

Posté par : agenda
Source : https://www.facebook.com